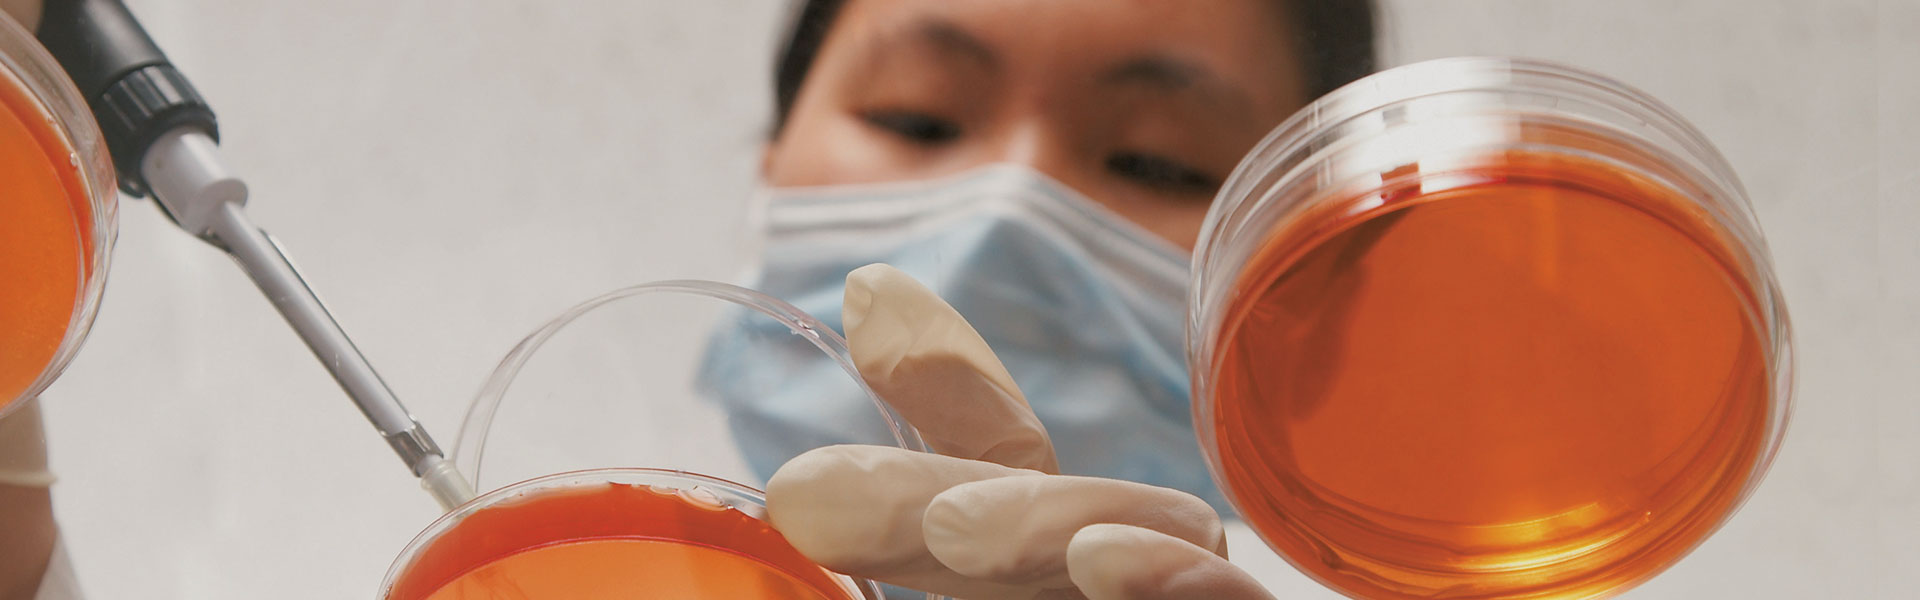
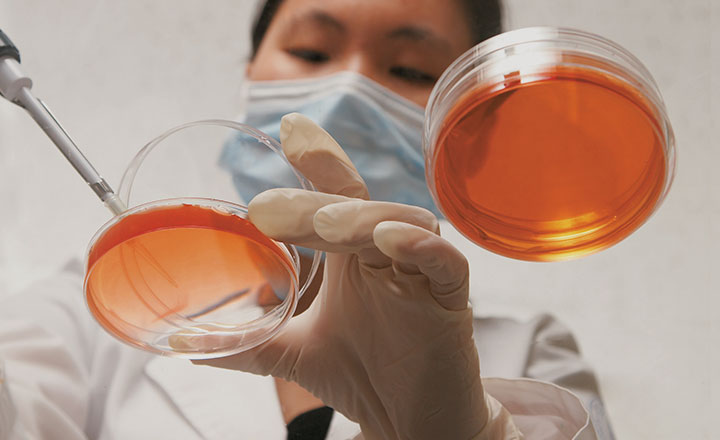

공지 사항
[통일보건의료센터] 제11회 세브란스 통일의 밤 - 숏폼 영상 공모전 참여 안내 [접수 기한: 11월 12일(수)까지]
공지 사항
[CAMPUS Asia사업] 2025년 하반기 CAMPUS Asia 사업 태국 출라롱콘대 단기교류 파견학생 모집 안내(~10/10(금) 17시까지)
세미나 강연
제24회 연세치의학 학술대회 및 연세치의학 110주년 기념 심포지엄
공지 사항
2026학년도 학생연구비 신청 안내
세미나 강연
International Symposium: Implant Dentistry for the Aging Population [9/13(토) ~ 9/14(일), 온라인]
공지 사항
2025-2학기 근로장학생 모집 안내